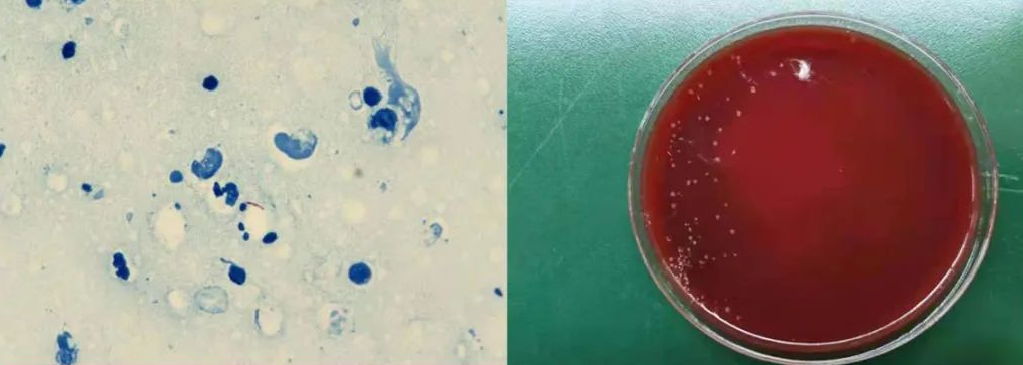
海分枝杆菌感染创口标本的抗酸染色涂片和在血平板上培养七天后的

海鱼分枝杆菌

组织培养分离出的海鱼分枝杆菌(抗酸染色×1000)
图片尺寸1000x695
海分枝杆菌感染1.jpg
图片尺寸456x402
医学科普·疾病知识文库:海鱼分枝杆菌感染.pdf 5页
图片尺寸792x1078
海鱼分枝杆菌感染吃什么药好
图片尺寸362x270
半滑舌鳎脾肾结节病原-海分枝杆菌
图片尺寸682x762
结核分枝杆菌的介绍
图片尺寸3264x2448
世界上最危险的10种细菌结核分枝杆菌位居榜首
图片尺寸630x438
海分枝杆菌感染创口标本的抗酸染色涂片和在血平板上培养七天后的
图片尺寸1023x365
海分枝杆菌感染3.jpg
图片尺寸412x332
非结核分枝杆菌病
图片尺寸2000x2000
基因突变会使儿童易感染分枝杆菌
图片尺寸413x275结核分枝杆菌
图片尺寸1200x800结核分枝杆菌
图片尺寸1200x800
麻风分枝杆菌(mycobacterium leprae)长久以来一直被认为是麻风病唯一
图片尺寸760x574结核分枝杆菌
图片尺寸1200x800
结核分枝杆菌图.图片来自:http://www.medi-learn.
图片尺寸600x450
结核分枝杆菌图片
图片尺寸450x300结核分枝杆菌
图片尺寸1200x800
结核分枝杆菌照片
图片尺寸450x300
结核分枝杆菌
图片尺寸785x525
猜你喜欢:海鱼分枝杆菌伤口图海洋分枝杆菌感染图片分枝杆菌海分枝杆菌肉芽肿图片海鱼分枝杆菌感染图片皮肤脓肿分枝杆菌感染海鱼分枝杆菌感染耻垢分枝杆菌牛分枝杆菌结核分枝杆菌菌落结核分枝杆菌麻风分枝杆菌非结核分枝杆菌结核分枝杆菌油镜结核分枝杆菌结构图结核分枝杆菌图片结核分枝杆菌镜下结核分枝杆菌抗酸麻风分枝杆菌图片分枝杆菌手绘图结核分枝杆菌绘图结核分枝杆菌显微镜分枝杆菌感染皮肤病图皮肤分枝杆菌感染表现结核分枝杆菌手绘结核分枝杆菌抗酸染色耻垢分枝杆菌手绘图结核分枝杆菌手绘图海鱼的品种结核分枝杆菌手绘图片守望先锋手机壁纸张雪大摩解构与重构设计 作品小红书可爱美甲景观平面图线稿 高清青凤赤牙cpYARiSL虎牙卡尔照片 真人李小胖排风管道消音器走心的句子霸气句子教你辨别牛里脊肉